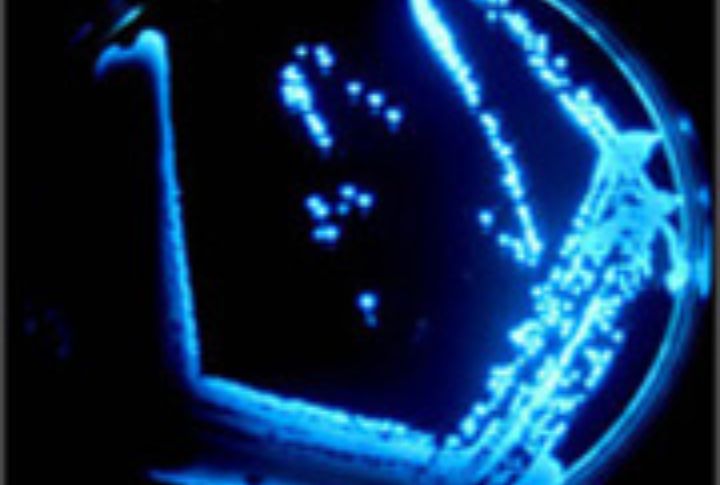

When night falls, nature unveils a world of glowing wonders. Bioluminescent creatures and environments light up the darkness, creating radiant displays that turn ordinary nights into something extraordinary. These rare phenomena showcase the brilliance hidden in the shadows. Here are some of nature’s true incandescent masterpieces.
Fireflies Shining Bright Through Summer Nights

A summer meadow flickers with the synchronized glow of fireflies, which is their signal to mate. Their light, a product of a chemical reaction involving luciferin, is visible across warm, humid regions like the Great Smoky Mountains in Tennessee, USA. Each flash pattern is species-specific and portrays a dazzling nighttime courtship ritual.
Glowing Fungi Brighten Forest Floors

In Australia, the ghost mushroom emits a faint greenish glow that pierces the night. Found primarily in forests in South Australia and Tasmania, an eerie light generated by luciferase enzymes attracts insects that help disperse fungal spores. Hikers often stumble upon their glow near logs that decay after sunset.
Bioluminescent Bays Sparkle at Night

Mosquito Bay in Puerto Rico glows brighter than any other bioluminescent bay on Earth. Tiny dinoflagellates emit blue-green light when disturbed, which looks like a trail of sparks behind paddles. Guinness World Records recognizes this bay as the brightest, a wonderful sight for kayakers under the stars.
Marine Plankton Light Up Ocean Waves

Rolling waves along California’s shores, especially at Torrey Pines and San Diego, glow electric blue as marine plankton ignite the surf. The microorganisms emit light as a defense mechanism to startle predators. A phenomenon that is vibrant during the late summer months.
Glow Worms Illuminate New Zealand Caves

Suspended like stars, glowworms in Waitomo Caves dangle silk threads that radiate light to lure insects. A bioluminescent display of the worms transforms subterranean exploration into an unforgettable natural light show. Thousands of visitors are drawn to the North Island of New Zealand.
Glowing Scorpions Under UV Light

Scorpions, found in deserts worldwide, emit an eerie blue-green glow under ultraviolet light. This phenomenon, caused by compounds in their exoskeleton, helps researchers locate them in the dark. Their glow may also act as a warning signal to predators or as a way to detect UV light in their environment.
Milky Seas Create Eerie Ocean Glow

Rare milky sea events stretch for miles, illuminating parts of the Indian Ocean, particularly near the coast of Somalia. Scientists attribute this mysterious glow to colonies of bioluminescent bacteria. Sailors have long reported these eerie phenomena, describing ghostly expanses of water that shimmer softly in the dark.
Radiant Algae Illuminate Coastal Waters

Tasmania’s coastline occasionally glows red due to bioluminescent algae known as “Noctiluca scintillans.” The algae’s glow deters predators and can signal algal blooms. The beaches near Hobart and Bruny Island are recommended destinations to witness this phenomenon.
Lanternfish Light Up the Deep Sea

Lanternfish, abundant in the deep waters off the coasts of Japan and the Atlantic Ocean, flash their photophores in mesmerizing patterns to confuse predators and communicate with one another. Their synchronized displays contribute to the breathtaking large-scale luminescence in the ocean’s mysterious twilight zone.
Brilliant Millipedes Illuminate Forest Floors

The Motyxia millipede, native to California’s Sierra Nevada mountains, emits a striking turquoise glow as a warning to nocturnal predators. This unique bioluminescent display becomes even more intense when the millipede feels threatened, signaling its potent toxicity to any would-be attackers.
The Subtle Luminescence of Sea Stars

Bioluminescence during nocturnal tides makes sea stars an unforgettable phenomenon. Like sea stars, Echinoderms emit faint light to confuse predators or signal mates. Their glow results from a unique chemical reaction on coral reefs and rocky shores. Have you ever seen the ocean shine brightly because of sea stars?
Glowing Jellyfish Drift Through Oceans

Crystal jellyfish near Vancouver Island and Monterey Bay produce bioluminescent flashes through specialized proteins. It’s a process that aids in defense and communication. Their translucent bodies light up when touched. It’s a pleasure to watch the flickers of displays that deter predators underwater.
Cave Ceilings Glowing with Bioluminescent Worms

Glowworms in New Zealand’s Ruakuri Caves produce a unique display with a blue-green light to attract prey. The bioluminescent larvae of the fungus gnat suspend sticky silk strands from cave ceilings to mimic starlight and lure insects. A phenomenon that draws thousands of visitors annually.
Glowing Coral Reefs Found Underwater Down Under

Some corals found in the Great Barrier Reef emit vibrant hues of orange and green when exposed to UV light during magical night dives. This stunning fluorescence comes from a protective layer that shields corals from intense sunlight and plays a vital role in the reef’s rich biodiversity.
Bioluminescent Shrimp Lighting up the Sea Floor

Snapping shrimp in the Caribbean and Gulf of Mexico emit brilliant bursts of light by rapidly snapping their claws together. The resulting shockwaves not only stun prey but also deter predators. These dazzling flashes can light up coral reefs, adding to their nighttime allure.
Glowing Snails in Deep Sea Waters

Clusterwink snails, found in the Indo-Pacific, emit quick bursts of blue-green light from their shells when disturbed. This bioluminescent display confuses predators and acts as a warning beacon, signaling danger. In the dark depths of reef environments, their glowing shells serve as a brilliant defense against attacks.
The Nighttime Beacons of Click Beetles

Click beetles, found in tropical regions like Central America, Southeast Asia, and Africa, light up the night with two glowing thorax spots. Their bioluminescence mimics poisonous fireflies, deterring predators, while their sharp “click” sound, made when flipping upright, adds to their impressive defense.
Glowing Squid Communicate Underwater

The firefly squid (Watasenia scintillans) lights up Toyama Bay in Japan during spring spawning. Photophores along its body create a bright blue glow, which confuses predators and helps attract mates. Thousands of tourists visit annually to witness this rare, vibrant spectacle.
Bioluminescent Bacteria Illuminate Marine Snow
Bioluminescent bacteria colonize organic particles that sink, known as marine snow, in the ocean’s depths. Colonization causes the particles to glow faintly for increased visibility. A process that can influence the ocean’s carbon cycle by affecting these particles’ consumption and decomposition rates.
Northern Lights Glow in Arctic Skies

The Northern Lights, or Aurora Borealis, paint Arctic skies with vibrant hues. This phenomenon occurs when charged solar particles collide with Earth’s magnetic field. Best seen in winter from Scandinavia or Alaska, these dancing lights captivate travelers seeking nature’s most dazzling celestial display.